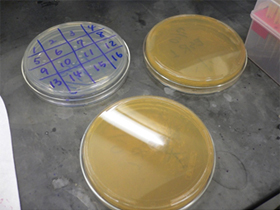

研究室の風景
設備
 共焦点レーザー顕微鏡 |
 試薬調整スペース |
 培養細胞取り扱いスペース |
 サーマルサイクラー 分光光度計 ナノドロップ |
 Image Quant LAS500(GE Healthcare) |
 UVイルミネーター(UVP) |
 Real-time PCR system (illumina) |
その他
 研究室からの眺め |
 |
 |
 |
 |
 |
 共焦点レーザー顕微鏡 |
 試薬調整スペース |
 培養細胞取り扱いスペース |
 サーマルサイクラー 分光光度計 ナノドロップ |
 Image Quant LAS500(GE Healthcare) |
 UVイルミネーター(UVP) |
 Real-time PCR system (illumina) |
 研究室からの眺め |
 |
 |
|
 |
 |